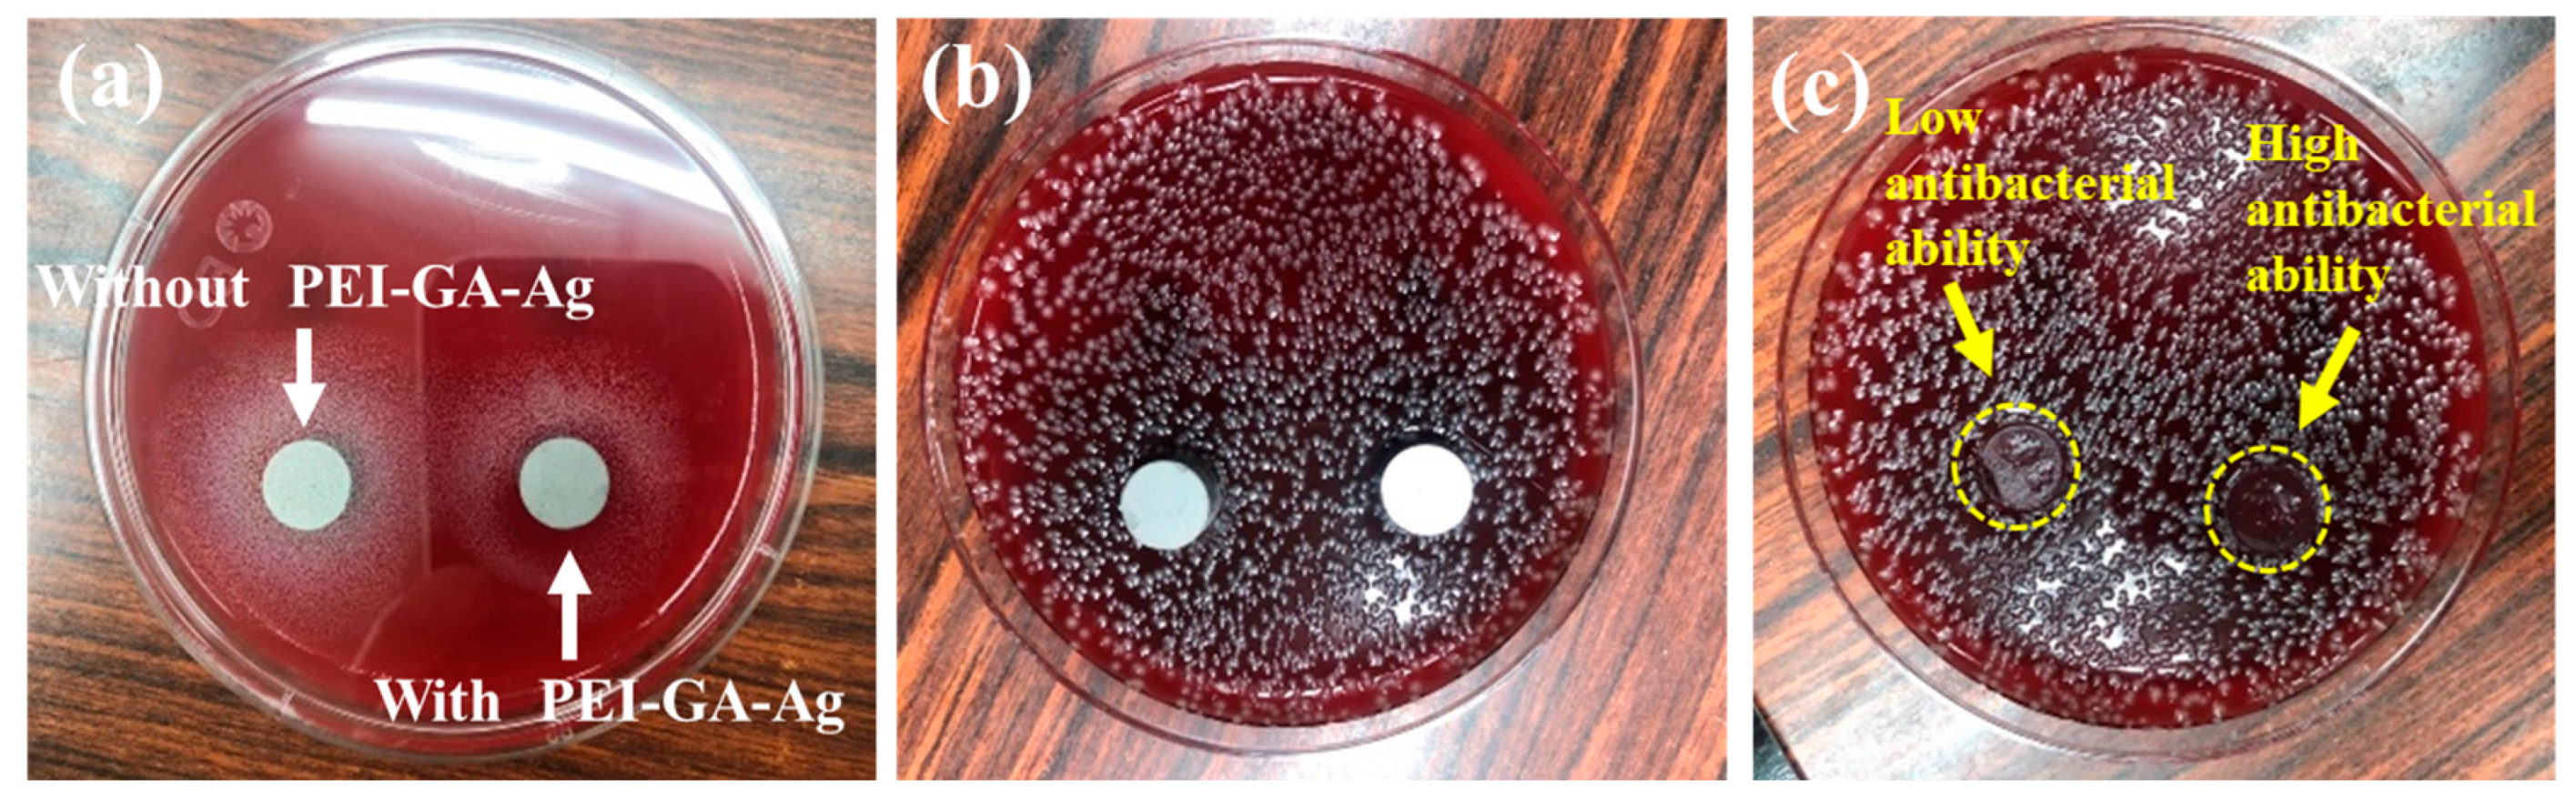
Materials 16 03719 g008 Materials 16 03719 g008

A Novel Method for the Fabrication of Antibacterial Stainless Steel with Uniform Silver Dispersions by Silver Nanoparticle/Polyethyleneimine Composites
Abstract
1. Introduction
2. Material and Methods
2.1. Preparation of Functionalized PEI-co-GA/Ag Catalyst
2.2. Electroless Silver Plating, Mirror Silver Reaction and Sintering
2.3. Characterizations
2.4. Evaluating Methods of Antibacterial Activity
3. Results and Discussion
3.1. Characterization of Chemical Silver Plating on Stainless Steel Powders without the Use of Functional Polymers
3.2. Introduction of Functional Polymers PEI-co-GA/Ag
3.3. Antibacterial Performance of 316LSS without/with PEI-co-GA/Ag
4. Conclusions
Author Contributions
Funding
Data Availability Statement
Conflicts of Interest
References
- Shaterian, M.; Khoobi, A.; Enhessari, M.; Ozaee, K. A new strategy based on thermodiffusion of ceramic nanopigments into metal surfaces and formation of anti-corrosion coatings. Microporous Mesoporous Mater. 2015, 218, 62–68. [Google Scholar] [CrossRef]
- Ahmed, N.; Barsoum, I.; Haidemenopoulos, G.; Al-Rub, R.A. Process parameter selection and optimization of laser powder bed fusion for 316L stainless steel: A review. J. Manuf. Process. 2022, 75, 415–434. [Google Scholar] [CrossRef]
- Borgioli, F. The “Expanded” phases in the low-temperature treated stainless steels: A review. Metals 2022, 12, 331. [Google Scholar] [CrossRef]
- Resnik, M.; Benčina, M.; Levičnik, E.; Rawat, N.; Iglič, A.; Junkar, I. Strategies for improving antimicrobial properties of stainless steel. Materials 2020, 13, 2944. [Google Scholar] [CrossRef]
- Getnet, T.G.; Kayama, M.E.; Rangel, E.C.; Duarte, I.C.; da Silva, G.F.; Cruz, N.C. Biofunctional coating of stainless steel surfaces with carvacrol-and eugenol-derived film using atmospheric dielectric barrier discharge plasma: Aiming for suppression of biofilm formation and corrosion protection. J. Mater. Res. Technol. 2022, 18, 2217–2231. [Google Scholar] [CrossRef]
- Dash, P.; Thirumurugan, S.; Hu, C.-C.; Wu, C.-J.; Shih, S.-J.; Chung, R.-J. Preparation and characterization of polyelectrolyte multilayer coatings on 316L stainless steel for antibacterial and bone regeneration applications. Surf. Coat. Technol. 2022, 435, 128254. [Google Scholar] [CrossRef]
- Huang, L.; Liu, C.-J. Progress for the development of antibacterial surface based on surface modification technology. Supramol. Mater. 2022, 1, 100008. [Google Scholar] [CrossRef]
- Campoccia, D.; Montanaro, L.; Arciola, C.R. A review of the biomaterials technologies for infection-resistant surfaces. Biomaterials 2013, 34, 8533–8554. [Google Scholar] [CrossRef]
- Wang, X.; Ye, X.; Zhang, L.; Shao, Y.; Zhou, X.; Lu, M.; Chu, C.; Xue, F.; Bai, J. Corrosion and antimicrobial behavior of stainless steel prepared by one-step electrodeposition of silver at the grain boundaries. Surf. Coat. Technol. 2022, 439, 128428. [Google Scholar] [CrossRef]
- Ren, G.; Huang, L.; Hu, K.; Li, T.; Lu, Y.; Qiao, D.; Zhang, H.; Xu, D.; Wang, T.; Li, T. Enhanced antibacterial behavior of a novel Cu-bearing high-entropy alloy. J. Mater. Sci. Technol. 2022, 117, 158–166. [Google Scholar] [CrossRef]
- Huang, H.; Barber, O.W.; Yu, Z.; Park, H.; Hu, X.; Chen, X.; Chen, C.H.; Hartmann, E.M.; Huang, J. Rub-Resistant Antibacterial Surface Conversion Layer on Stainless Steel. Adv. Mater. Interfaces 2022, 9, 2200251. [Google Scholar] [CrossRef]
- Kuo, Y.-J.; Chen, C.-H.; Dash, P.; Lin, Y.-C.; Hsu, C.-W.; Shih, S.-J.; Chung, R.-J. Angiogenesis, osseointegration, and antibacterial applications of polyelectrolyte multilayer coatings incorporated with silver/strontium containing mesoporous bioactive glass on 316L stainless steel. Front. Bioeng. Biotechnol. 2022, 10, 818137. [Google Scholar] [CrossRef] [PubMed]
- Dediu, V.; Busila, M.; Tucureanu, V.; Bucur, F.I.; Iliescu, F.S.; Brincoveanu, O.; Iliescu, C. Synthesis of ZnO/Au Nanocomposite for Antibacterial Applications. Nanomaterials 2022, 12, 3832. [Google Scholar] [CrossRef] [PubMed]
- Zhang, S.; Yu, Y.; Wang, H.; Ren, L.; Yang, K. Study on mechanical behavior of Cu-bearing antibacterial titanium alloy implant. J. Mech. Behav. Biomed. Mater. 2022, 125, 104926. [Google Scholar] [CrossRef] [PubMed]
- Rodríguez-Barajas, N.; Becerra-Solano, L.; Gutiérrez-Mercado, Y.K.; Macías-Carballo, M.; Gómez, C.M.; Pérez-Larios, A. Study of the Interaction of Ti–Zn as a Mixed Oxide at Different pH Values Synthesized by the Sol–Gel Method and Its Antibacterial Properties. Nanomaterials 2022, 12, 1948. [Google Scholar] [CrossRef]
- Isopencu, G.; Mocanu, A. Recent Advances in Antibacterial Composite Coatings. Coatings 2022, 12, 1504. [Google Scholar] [CrossRef]
- Makowski, T.; Svyntkivska, M.; Piorkowska, E.; Mizerska, U.; Fortuniak, W.; Kowalczyk, D.; Brzezinski, S.; Kregiel, D. Antibacterial electroconductive composite coating of cotton fabric. Materials 2022, 15, 1072. [Google Scholar] [CrossRef]
- Eto, S.; Kawano, S.; Someya, S.; Miyamoto, H.; Sonohata, M.; Mawatari, M. First clinical experience with thermal-sprayed silver oxide–containing hydroxyapatite coating implant. J. Arthroplast. 2016, 31, 1498–1503. [Google Scholar] [CrossRef]
- Hermawan, H. Updates on the research and development of absorbable metals for biomedical applications. Prog. Biomater. 2018, 7, 93–110. [Google Scholar] [CrossRef]
- Noronha, V.T.; Paula, A.J.; Durán, G.; Galembeck, A.; Cogo-Müller, K.; Franz-Montan, M.; Durán, N. Silver nanoparticles in dentistry. Dent. Mater. 2017, 33, 1110–1126. [Google Scholar] [CrossRef]
- Zhang, K.; Melo, M.A.S.; Cheng, L.; Weir, M.D.; Bai, Y.; Xu, H.H. Effect of quaternary ammonium and silver nanoparticle-containing adhesives on dentin bond strength and dental plaque microcosm biofilms. Dent. Mater. 2012, 28, 842–852. [Google Scholar] [CrossRef] [PubMed]
- Calfee, M.W.; Ryan, S.P.; Abdel-Hady, A.; Monge, M.; Aslett, D.; Touati, A.; Stewart, M.; Lawrence, S.; Willis, K. Virucidal efficacy of antimicrobial surface coatings against the enveloped bacteriophage Φ6. J. Appl. Microbiol. 2022, 132, 1813–1824. [Google Scholar] [CrossRef] [PubMed]
- Ma, C.; Nikiforov, A.; De Geyter, N.; Morent, R.; Ostrikov, K.K. Plasma for biomedical decontamination: From plasma-engineered to plasma-active antimicrobial surfaces. Curr. Opin. Chem. Eng. 2022, 36, 100764. [Google Scholar] [CrossRef]
- Malvi, B.; Chaudhari, R.; Balasubramanian, C.; Kumar, A.; Asokan, K.; Das, S.; Paliwal, M.; Misra, S.K. Ion implantation of 109Ag stable isotope as a tracer in SS316L biomedical implant for failure detection. Mater. Today Commun. 2022, 33, 104563. [Google Scholar] [CrossRef]
- Karabulut, G.; Üllen, N.B.; Akyüz, E.; Karakuş, S. Surface modification of 316L stainless steel with multifunctional locust gum/polyethylene glycol-silver nanoparticles using different coating methods. Prog. Org. Coat. 2023, 174, 107291. [Google Scholar] [CrossRef]
- Calovi, M.; Rossi, S. Durability of Acrylic Cataphoretic Coatings Additivated with Colloidal Silver. Coatings 2022, 12, 486. [Google Scholar] [CrossRef]
- Kultamaa, M.; Gunell, M.; Mönkkönen, K.; Suvanto, M.; Saarinen, J.J. Antimicrobial activity of porous metal injection molded (MIM) 316L stainless steel by Zn, Cu and Ag electrodeposition. Surf. Interfaces 2023, 38, 102778. [Google Scholar] [CrossRef]
- Ahn, S.-J.; Lee, S.-J.; Kook, J.-K.; Lim, B.-S. Experimental antimicrobial orthodontic adhesives using nanofillers and silver nanoparticles. Dent. Mater. 2009, 25, 206–213. [Google Scholar] [CrossRef]
- Skiba, M.; Pivovarov, A.; Vorobyova, V.; Derkach, T.; Kurmakova, I. Plasma-chemical formation of silver nanoparticles: The silver ions concentration effect on the particle size and their antimicrobial properties. J. Chem. Technol. Metall. 2019, 54, 311–318. [Google Scholar]
- Liao, K.-H.; Ou, K.-L.; Cheng, H.-C.; Lin, C.-T.; Peng, P.-W. Effect of silver on antibacterial properties of stainless steel. Appl. Surf. Sci. 2010, 256, 3642–3646. [Google Scholar] [CrossRef]
- Yokota, T.; Tochihara, M.; Ohta, M. Silver dispersed stainless steels with antibacterial property. Kawasaki Steel Giho 2001, 33, 88–91. [Google Scholar]
- Liu, L.; Li, Y.; Yu, K.; Zhu, M.; Jiang, H.; Yu, P.; Huang, M. A novel stainless steel with intensive silver nanoparticles showing superior antibacterial property. Mater. Res. Lett. 2021, 9, 270–277. [Google Scholar] [CrossRef]
- You, J.-L.; Chen, Y.-S.; Chang, C.-P.; Wu, M.-Z.; Ger, M.-D. Utilizing a pH-responsive palladium nanocomposite to fabricate adhesion-enhanced and highly reliable copper coating on nylon 6 fabrics. J. Mater. Res. Technol. 2021, 15, 3983–3994. [Google Scholar] [CrossRef]
- You, J.-L.; Chang, C.-P.; Youh, M.-J.; Wu, M.-Z.; Chen, Y.-S.; Ger, M.-D. A reliable method by utilizing thermo-responsive palladium nanocomposite for fabricating Nickel coating on nylon 6 fabrics. Colloids Surf. A Physicochem. Eng. Asp. 2022, 655, 130160. [Google Scholar] [CrossRef]
- Liao, Y.; Wang, Y.; Feng, X.; Wang, W.; Xu, F.; Zhang, L. Antibacterial surfaces through dopamine functionalization and silver nanoparticle immobilization. Mater. Chem. Phys. 2010, 121, 534–540. [Google Scholar] [CrossRef]
- Ren, C.; Li, X.; Mao, L.; Xiong, J.; Gao, C.; Shen, H.; Wang, L.; Zhu, D.; Ding, W.; Wang, H. An effective and biocompatible polyethylenimine based vaginal suppository for gene delivery. Nanomed. Nanotechnol. Biol. Med. 2019, 20, 101994. [Google Scholar] [CrossRef]
- Wang, X.; Yan, H.; Hang, R.; Shi, H.; Wang, L.; Ma, J.; Liu, X.; Yao, X. Enhanced anticorrosive and antibacterial performances of silver nanoparticles/polyethyleneimine/MAO composite coating on magnesium alloys. J. Mater. Res. Technol. 2021, 11, 2354–2364. [Google Scholar] [CrossRef]
- Kotta, M.; Gorantla, S.; Muddada, V.; Lenka, R.R.; Karri, T.; Kumar, S.; Tivanani, M. Antibacterial activity and debonding force of different lingual retainers bonded with conventional composite and nanoparticle containing composite: An in vitro study. J. World Fed. Orthod. 2020, 9, 80–85. [Google Scholar] [CrossRef]
- Dias, H.B.; Bernardi, M.I.B.; Bauab, T.M.; Hernandes, A.C.; de Souza Rastelli, A.N. Titanium dioxide and modified titanium dioxide by silver nanoparticles as an anti biofilm filler content for composite resins. Dent. Mater. 2019, 35, e36–e46. [Google Scholar] [CrossRef]
- Hudzicki, J. Kirby-Bauer disk diffusion susceptibility test protocol. Am. Soc. Microbiol. 2009, 15, 55–63. [Google Scholar]
- Nakahata, T.; Ogawa, M. Identification in culture of a class of hemopoietic colony-forming units with extensive capability to self-renew and generate multipotential hemopoietic colonies. Proc. Natl. Acad. Sci. USA 1982, 79, 3843–3847. [Google Scholar] [CrossRef] [PubMed]
- Wang, J.; Wang, H.; Zhao, P.; Chen, Z.; Lin, Q. Hyperbranched-star PEI-g-PEG as a nonviral vector with efficient uptake and hypotoxicity for retinoblastoma gene therapy application. Colloid Interface Sci. Commun. 2022, 50, 100647. [Google Scholar] [CrossRef]
- Wang, C.; Yin, J.; Han, S.; Jiao, T.; Bai, Z.; Zhou, J.; Zhang, L.; Peng, Q. Preparation of palladium nanoparticles decorated polyethyleneimine/polycaprolactone composite fibers constructed by electrospinning with highly efficient and recyclable catalytic performances. Catalysts 2019, 9, 559. [Google Scholar] [CrossRef]
- Wang, X.; Fang, X.; Gao, X.; Wang, H.; Li, S.; Li, C.; Qing, Y.; Qin, Y. Strong adhesive and drug-loaded hydrogels for enhancing bone–implant interface fixation and anti-infection properties. Colloids Surf. B Biointerfaces 2022, 219, 112817. [Google Scholar] [CrossRef] [PubMed]
- Géczi, Z.; Hermann, P.; Kőhidai, L.; Láng, O.; Kőhidai, Z.; Mészáros, T.; Barócsi, A.; Lenk, S.; Zelles, T. Antimicrobial silver-polyethyleneimine-polylactic acid polymer composite film for coating methacrylate-based denture surfaces. J. Nanomater. 2018, 2018, 1048734. [Google Scholar] [CrossRef]
- Farmanbar, M.; Brocks, G. First-principles study of van der Waals interactions and lattice mismatch at MoS2/metal interfaces. Phys. Rev. B 2016, 93, 085304. [Google Scholar] [CrossRef]
- Liu, T.; Rao, Y.; Zhou, W.; Zhuang, W.; Ge, L.; Lin, R.; Zhang, W.; Wu, J.; Zhu, C.; Ying, H. Improved adenylate cyclase activity via affinity immobilization onto co-modified GO with bio-inspired adhesive and PEI. Colloids Surf. B Biointerfaces 2021, 205, 111888. [Google Scholar] [CrossRef]
- Matindi, C.N.; Kadanyo, S.; Liu, G.; Hu, M.; Hu, Y.; Cui, Z.; Ma, X.; Yan, F.; He, B.; Li, J. Hydrophilic polyethyleneimine-TiO2 hybrid layer on polyethersulfone/sulfonated polysulfone blend membrane with antifouling characteristics for the effective separation of oil-in-water emulsions. J. Water Process Eng. 2022, 49, 102982. [Google Scholar] [CrossRef]
- Yang, Y.-H.; Haile, M.; Park, Y.T.; Malek, F.A.; Grunlan, J.C. Super gas barrier of all-polymer multilayer thin films. Macromolecules 2011, 44, 1450–1459. [Google Scholar] [CrossRef]
- Wang, S.; Xiao, K.; Mo, Y.; Yang, B.; Vincent, T.; Faur, C.; Guibal, E. Selenium (VI) and copper (II) adsorption using polyethyleneimine-based resins: Effect of glutaraldehyde crosslinking and storage condition. J. Hazard. Mater. 2020, 386, 121637. [Google Scholar] [CrossRef]
- Wang, X.; Xie, P.; He, L.; Liang, Y.; Zhang, L.; Miao, Y.; Liu, Z. Ultralight, mechanically enhanced, and thermally improved graphene-cellulose-polyethyleneimine aerogels for the adsorption of anionic and cationic dyes. Nanomaterials 2022, 12, 1727. [Google Scholar] [CrossRef] [PubMed]
- Hemmingson, S.L.; Campbell, C.T. Trends in adhesion energies of metal nanoparticles on oxide surfaces: Understanding support effects in catalysis and nanotechnology. ACS Nano 2017, 11, 1196–1203. [Google Scholar] [CrossRef] [PubMed]
- Biemer, J.J. Antimicrobial susceptibility testing by the Kirby-Bauer disc diffusion method. Ann. Clin. Lab. Sci. 1973, 3, 135–140. [Google Scholar] [PubMed]
- Prockop, D.J.; Phinney, D.G.; Bunnell, B.A. Mesenchymal Stem Cells: Methods and Protocols; Springer: Berlin/Heidelberg, Germany, 2008; Volume 192. [Google Scholar]

| CFU COUNT 1 | CFU COUNT 2 | CFU COUNT 3 | Mean | LOG | UP | Down | |
|---|---|---|---|---|---|---|---|
| 316SS | 156,000 | 165,000 | 134,000 | 151,667 | 5.18 | 0.037 | 0.05 |
| 316SS + PEI-co-GA/Ag | 10,500 | 12,300 | 19,950 | 14,250 | 4.15 | 0.146 | 0.13 |
Disclaimer/Publisher’s Note: The statements, opinions and data contained in all publications are solely those of the individual author(s) and contributor(s) and not of MDPI and/or the editor(s). MDPI and/or the editor(s) disclaim responsibility for any injury to people or property resulting from any ideas, methods, instructions or products referred to in the content. |
© 2023 by the authors. Licensee MDPI, Basel, Switzerland. This article is an open access article distributed under the terms and conditions of the Creative Commons Attribution (CC BY) license (https://creativecommons.org/licenses/by/4.0/).
Share and Cite
Chih, Y.-K.; You, J.-L.; Lin, W.-H.; Chang, Y.-H.; Tseng, C.-C.; Ger, M.-D. A Novel Method for the Fabrication of Antibacterial Stainless Steel with Uniform Silver Dispersions by Silver Nanoparticle/Polyethyleneimine Composites. Materials 2023, 16, 3719. https://doi.org/10.3390/ma16103719
Chih Y-K, You J-L, Lin W-H, Chang Y-H, Tseng C-C, Ger M-D. A Novel Method for the Fabrication of Antibacterial Stainless Steel with Uniform Silver Dispersions by Silver Nanoparticle/Polyethyleneimine Composites. Materials. 2023; 16(10):3719. https://doi.org/10.3390/ma16103719
Chicago/Turabian StyleChih, Yu-Kun, Jhu-Lin You, Wei-Hsuan Lin, Yen-Hao Chang, Chun-Chieh Tseng, and Ming-Der Ger. 2023. "A Novel Method for the Fabrication of Antibacterial Stainless Steel with Uniform Silver Dispersions by Silver Nanoparticle/Polyethyleneimine Composites" Materials 16, no. 10: 3719. https://doi.org/10.3390/ma16103719
APA StyleChih, Y.-K., You, J.-L., Lin, W.-H., Chang, Y.-H., Tseng, C.-C., & Ger, M.-D. (2023). A Novel Method for the Fabrication of Antibacterial Stainless Steel with Uniform Silver Dispersions by Silver Nanoparticle/Polyethyleneimine Composites. Materials, 16(10), 3719. https://doi.org/10.3390/ma16103719

